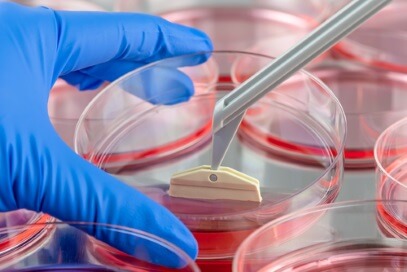

Medical Engineering (Cell and Tissue Engineering for Regenerative Medicine) MSc
Medical Engineering (Cell and Tissue Engineering for Regenerative Medicine) - MSc
Regenerative medicine is reshaping clinical medicine as we know it, uncovering new ways to replace, engineer or regenerate cells, tissues and organs lost or injured due to age, disease, or congenital defects. One of the longest-running courses of its kind in the UK, our MSc builds on our reputation for world-class research as a European Centre for Excellence in tissue engineering. Our multidisciplinary course provides a solid foundation in cell biology, human anatomy, physiology and molecular techniques, introducing you to stem cell/gene therapies, new implants, bio/tissue engineering, biomaterials and other novel technologies in this rapidly evolving and exciting discipline.
Month of entry
- September, January
Mode of study
- Full time, Part time
Location
Subject area
- Bioengineering
Fees for 2026/27 academic year
- UK - Full time £11,700 per year. Part time £6,400 per year.
International - £18,200 per year.
Duration of study
- 1 year full time, 2 years part time (UK students)
This course is no longer accepting applications from international students for the 2026/27 academic year.
This programme is no longer accepting international applications for September 2026
Why study Medical Engineering (Cell and Tissue Engineering for Regenerative Medicine) at Keele University?
Course summary
Cell and tissue engineering has the potential to unlock new treatments for some of the biggest health issues facing society, for diseases of the heart, lungs, eyes, muscle, bone, etc as well as offering possibilities for repairing or regenerating cells of the body, joints and organs.
Capitalising on our exceptional track record of bench and bedside research in regenerative medicine, our MSc introduces you to this dynamic, ever-evolving discipline, which is bringing hope to millions of patients worldwide.
Practical in focus, you’ll gain a solid grounding in cell biology, human anatomy and physiology, and molecular techniques, as well as advanced knowledge of topics in biomaterials, nanotechnology, cell and tissue engineering.
You’ll learn to research strategies to repair, replace and ultimately regenerate various tissues and organs, translating fundamental knowledge in physics, chemistry and biology into practical and effective materials, devices, novel therapies and treatments to solve major clinical problems.
Based in the Guy Hilton Research Centre, you’ll have access to cutting-edge multi-disciplinary research into specialist and novel areas of regenerative medicine with the opportunity to conduct an in-depth research project alongside our world-class researchers. Previous student dissertation projects, for example, have included genetic engineering of heart cells, nanomagnetics for cancer treatment, and 3D bioprinting for disease modelling.
Research at Keele encompasses tissue engineering for the study of cardiovascular diseases and nanotechnology to control behaviour of cells in cases of neural injury or neurodegenerative diseases, such as Parkinson’s. And, as part of the Versus Arthritis Tissue Engineering and Regenerative Therapies Centre, our researchers work on cell therapy treatments to regenerate damaged bones, joints and muscles in patients with osteoarthritis and rheumatoid arthritis.
As well as excellent preparation for PhD study, this MSc responds to the growing demand for specialists in the rapidly expanding field of stem cells, regenerative medicine, cancer, material science, bio/tissue engineering and associated novel technologies. It can lead to exciting careers in clinical research, technology development, bioprocessing, therapeutics and regenerative medicine within healthcare, life science and medical-related industry or academia.
Related courses

"Cell and Tissue Engineering course at Keele seemed like the perfect choice due to the amazing research facilities and ability to personalise the module choices to suit my interest. During my studies I was able to acquire plenty of invaluable experience from the students and the staff working at the Research Institute and also develop personally through the attendance of seminars, workshops and journal club."
Course structure
The programme is designed to provide the necessary knowledge and skills to understand various diseases and disorders with a view to producing drug, cell or gene-based therapies. You’ll cover the full spectrum of activity, from clinical-focused research at the cell-level, right through to biotechnology and engineering, producing the regenerative products of the future.
You’ll be exposed to real research within various medical fields and cutting-edge molecular techniques in cell and tissue engineering, including stem cell engineering, tissue engineering with nanomaterials, bioreactors, 3D bioprinting, CRISPR genetic engineering, optogenetics, and nanomedicine.
The flexible structure of the course enables you to personalise your study according to your interests, choosing optional modules from a broad range of subjects, which span the disciplines of biology, maths and engineering. This, coupled with clinical visits, specialist seminars and a choice of dissertation projects that span fundamental research to clinical translation of technologies, ensures a truly ‘bench to bedside’ approach.
Interacting with active researchers, clinicians and practitioners also gives you a greater appreciation of the context in which healthcare engineering operates, including vital safety, environmental and economic concerns, for instance, in relation to medical devices and technology services.
The MSc Medical Engineering (Cell and Tissue Engineering for Regenerative Medicine) can be studied as either a one year full-time or a two year part-time course, usually starting in September. We also have an additional intake in January. You will complete 180 credits to obtain the master’s qualification, comprising seven compulsory modules and two optional modules. This includes the core Project Dissertation module which accounts for 60 credits. There are also two interim awards available, depending on how many modules (and credits) have been successfully completed: a Postgraduate Certificate for 60 credits; and a Postgraduate Diploma for 120 credits. For January intake (students starting from Semester 2 in January), students will proceed as per module and assessment schedule in the respective semesters of a standard September start, except that for these students course runs from January to December (exception to MTE-40055 assessment outlined below).
Modules
The module details given below are indicative, they are intended to provide you with an idea of the range of subjects that are taught to our current students. The modules that will be available for you to study in future years are prone to change as we regularly review our teaching to ensure that it is up-to-date and informed by the latest research and teaching methods, as well as student voice. The information presented is therefore not intended to be construed and/or relied upon as a definitive list of the modules available in any given year.
Core modules
MTE-40028 Stem Cells: Types, Characteristics and Applications (15 credits, Semester 1)
The field of stem cell biology is fast-paced with state-of-the-art research being competitively conducted across the world. On this module, you’ll draw on up-to-date international research in stem cell biology to build your knowledge from basic principles of stem cell isolation and differentiation, right through to the latest therapeutic use of stem cells trending in the field. The lecture series is delivered by leading academic researchers. To complement your understanding of the knowledge learned in class, you'll be trained in advanced practical skills in a state-of-the-art stem cell laboratory, using the latest approaches in the field. Gaining a greater appreciation of the diversity of stem cells and their potential, this module provides a basic foundation for regenerative medicine.
MTE-40033 Cell and Tissue Engineering (15 credits, Semester 1)
Cell and tissue engineering is a rapidly evolving discipline which promises to change the way clinicians deliver therapies and treat disorders of various kinds, from bone tissue engineering to skin grafts. Highlighting the latest research findings in engineering various cells, tissues and organs, you’ll be introduced to current concepts and methods used to apply and evaluate stimulus to cells to construct bioartificial tissues in vitro or alter cell growth and function in vivo by implanting donor tissue or biocompatible materials.
MTE-40022 Bioreactors and Growth Environments (15 credits, Semester 2)
The global bioreactors market is predicted to grow 14% between 2022 to 2029; fuelled by increases in conditions like arthritis, cancer and diabetes and the resulting demand for effective vaccines and treatments. This module covers the design principles and functionality of bioreactors used, for example, to grow organisms for cell development and product formation. As well as demonstrations on the workings of a range of research laboratory and good manufacturing practice (GMP) grade bioreactor systems used in academia and industry, you’ll be introduced to current real-world applications of bioreactors in regenerative medicine through a series of seminar-style presentations from national and international renowned researchers and industry. As part of the module, Keele hosts a renowned workshop that includes talks on a variety of bioreactors used for therapy, research and in industry, which also attracts national and international external participants, culminating in a 'design your own bioreactor' activity.
MTE-40036 Biomaterials (15 credits, Semester 2)
Taking a multidisciplinary approach, this module provides an overview of all types of materials, natural and synthetic, used in biological environments to support, enhance, or replace damaged tissue or a biological function. It explains the fundamental aspects of biomaterials from a materials perspective, but with particular focus on their use and potential wear within a biological ‘host’. You will develop a systematic knowledge, ranging from the physical structure and chemical properties of biomaterials, to how they interact with biological tissues during implantation, for example, in the case of skin grafts, heart valves and hip replacements. This will help you learn how materials are assessed within the clinic and how material properties can be altered/engineered to produce biomaterials with enhanced abilities and properties.
MTE-40039 Experimental Research Methodology (15 credits, semester 1-2)
Developing the academic skillset required for your master’s research and future scientific career, you’ll gain a strong grounding in appropriate level literature search, academic writing, statistical evaluation and manipulation of data. From learning how to take notes in research seminars, to managing your time efficiently in written examinations and writing a comprehensive literature review, this module addresses your personal and professional development. Research seminars provide direct access to innovative research, with students introduced to trending research topics in areas of cancer, neuroscience, heart, lung, drug development, nanomaterials, medical device and biomedical engineering, by national and international speakers. The module also includes a statistics workshop and sessions to improve soft skills to support the theoretical and practical aspects of the course.
MTE-40055 Disease Modelling & Therapy for Regenerative Medicine (15 credits, Semester 1-2)
This recently added core module in the MSc Cell & Tissue Engineering portfolio draws upon the current trends in Regenerative Medicine research by applying translational cell biology for personalised medicine through disease modelling and therapy. This capstone module captures key elements from the many CTE core modules and aims to connect student learning and entrepreneurial skills for addressing demands of the Regenerative Medicine field. This is a fast-paced area of medicine in the 21st century with the global regenerative medicine market size expected to reach USD 172.15 billion by 2030, in response to the growing demand for novel regenerative therapies. Through translational learning and entrepreneurial skills which this module offers, it exposes students to creative ideas for addressing current diseases and their treatments, using relevant disease models and using cell, gene and drug therapies. The students are broadly assessed on their application of knowledge through case studies and skills acquired through a practical session on cutting-edge CRISPR gene engineering. The vocational aspect through a business plan delivers practical awareness of strategies, regulations and policies to take their innovative ideas of chosen model/therapy to market and defend their ideas in a ‘Dragon’s Den’ style competition in front of a panel of experts from industry, academia and clinic. Entrepreneurial training is supported by attending the nationally-acclaimed YES programme (The Young Entrepreneurs Scheme) that all students will automatically enrol into, on admission to this course. For January intake (students starting from Semester 2 in January), students taking MTE-40055 will have their assessments in final semester.
MTE-40015 Project (Dissertation) (60 credits, Semester 3)
Representing the culmination of your studies, the Project provides an exciting opportunity to undertake laboratory-based research under the supervision of an expert in an agreed field of interest, based here in the Research Institute, a local hospital or within a collaborating industrial partner or clinical team. Applying the skills and knowledge gained throughout the course, you will design, conduct research and produce a 15,000-20,000-word dissertation. Projects cover a span of research interests related to Keele expertise in the fields of stem cells, biomaterials, heart and lung disease models, genetics, cancer biology, neuroscience and drug development/screening.
Optional modules
You will choose two optional modules from the following:
PHA-40236 Biotechnology and Omics (15 credits, Semester 1)
This module provides students a platform for bridging basic understanding in molecular techniques or data science to advanced biotechnology and multi-omics methods. The exposure to current trends and training in the module provide students with advanced understanding and skills to apply their knowledge in future for precision medicine, a trend in regenerative medicine, biomedical, pharmaceutical and healthcare fields. The module will be delivered through a combination of lectures, tutorials and practical with interactive pedagogical sessions to support their learning. Students will be exposed to conventional or state-of-the-art techniques in gene and cell engineering including CRISPR/RNA engineering, 3D bioprinting, protein and antibody engineering, etc. Multi-omics approaches studied will include genomics, metabolomics, proteomics, etc, for purpose of disease stratification and personalized medicine. Practical will focus on a biotechnological approach (qPCR or metabolomics, etc) for applying their learning.
MTE-40026 Physiological Measurements (15 credits, Semester 1-2)
Learning why and how physiological processes of humans are measured and monitored, this module aims to improve your analytical skills in different physiological measurement, diagnostics and therapy techniques. Studying the basic principles of biological sensing within research and clinical environments, you’ll be given demonstrations and hands-on use of devices commonly used for physiological measurement, such as the use of biomedical transducers, biosensors, devices for oscillometry, ECG (electrocardiogram) and EOG (electrooculography). To help you better understand how to select appropriate biological tests and devices, you will discuss and evaluate the different instrumentation used to assess specific anatomical structures, such as the heart and lungs, to measure their physiological properties by medics and in biomedical research.
MTE-40030 Nanomagnetics in Nanomedicine (15 credits, Semester 2)
The application of nanotechnologies, in particular the use of nanoparticles to improve the behaviour of drug substances, is being used globally to improve the treatments for patients suffering from disorders including ovarian and breast cancer, kidney disease, fungal infections, and more. Now, the sub-field of nanomagnetics is playing a major role in the development of new technologies for the assessment and therapeutic treatment of biological tissues. For example, rapidly reversing the magnetic field of nanoparticles injected into a tumour generates enough heat to kill cancer cells. Delivered through a series of lectures working at the interface of physics and biology, this module introduces you to the theoretical concepts of nanomagnetism and the state-of-the-art research in this field.
Entry requirements
The following section details our typical entry requirements for this course for a range of UK and international qualifications. If you don't see your qualifications listed, please contact us to find out if we can accept your qualifications.
Typical offer
Please ensure that you read the full entry requirements by selecting your qualifications from the dropdown menu below. This will include any subject specific, GCSE/Level 2 Maths, and English language requirements you may need.
Please select your country from the drop-down list below for the full entry requirement information
UK
2:2 degree in an engineering, science, medicine, or health subject
or
demonstrated professional or relevant qualifications or experience
You will also need: an English language qualification (see below)
Algeria
12/20 or Assez Bien degree in an engineering, science, medicine, or health subject
or
demonstrated professional or relevant qualifications or experience
You will also need: an English language qualification (see below)
Bahrain
Bachelor's degree with a minimum CGPA of 2.7/4.0 in an engineering, science, medicine, or health subject
or
demonstrated professional or relevant qualifications or experience
You will also need: an English language qualification (see below)
Bangladesh
60% in a 4-year degree or 3-year degree with a 2-year Master's in an engineering, science, medicine, or health subject from a public university
or
CGPA 2.8 in a 4-year degree or 3-year degree with a 2-year Master's in an engineering, science, medicine, or health subject from a private university
or
demonstrated professional or relevant qualifications or experience
We don’t accept degrees from certain universities, please see our Bangladesh Country Page for more information
You will also need: an English language qualification (see below)
Canada
70% or C or a GPA of 2.5 in a degree (Ordinary or Honours) in an engineering, science, medicine or health subject
or
demonstrated relevant professional qualifications or experience
You will also need: an English language qualification (see below)
China
70% in a degree in an engineering, science, medicine, or health subject
or
65% in a degree in an engineering, science, medicine, or health subject from a '211' university
or
demonstrated professional or relevant qualifications or experience
You will also need: an English language qualification (see below)
Egypt
Bachelor degree from a Public or Private University with 65%/CGPA = 2.7/Good degree in an engineering, science, medicine, or health subject
or
demonstrated professional or relevant qualifications or experience
You will also need: an English language qualification (see below)
Ghana
Second class degree in an engineering, science, medicine, or health subject
or
demonstrated professional or relevant qualifications or experience
You will also need: an English language qualification (see below)
Hong Kong
Bachelor's Honours degree with 2:2 or CGPA of 2.5 OR Bachelor Ordinary degree with a CGPA of 3.4 in an engineering, science, medicine, or health subject
or
demonstrated professional or relevant qualifications or experience
You will also need: an English language qualification (see below)
India
55% or CGPA 6/10 in a degree of at least 3 years in an engineering, science, medicine, or health subject
or
demonstrated professional or relevant qualifications or experience
You will also need: an English language qualification (see below)
Kenya
Second class degree in an engineering, science, medicine, or health subject
or
demonstrated professional or relevant qualifications or experience
You will also need: an English language qualification (see below)
Kuwait
Bachelor's degree with a minimum CGPA of 2.75/4.0 or 3.5/5.0 in an engineering, science, medicine, or health subject
or
demonstrated professional or relevant qualifications or experience
You will also need: an English language qualification (see below)
Nepal
60% / 2.4 in a 4-year Bachelor's degree in an engineering, science, medicine, or health subject
or
65% / CGPA 2.8 in a 3-year Bachelor's degree in an engineering, science, medicine, or health subject
or
demonstrated professional or relevant qualifications or experience
You will also need: an English language qualification (see below)
Nigeria
Second class degree in an engineering, science, medicine, or health subject
or
demonstrated professional or relevant qualifications or experience
You will also need: an English language qualification (see below)
Oman
Bachelor's degree with a minimum CGPA of 2.5/4.0 in an engineering, science, medicine, or health subject
or
demonstrated professional or relevant qualifications or experience
You will also need: an English language qualification (see below)
Pakistan
We accept a range of qualifications from Pakistan. Please visit our Pakistan Country Page for more information
or we will consider demonstrated relevant professional qualifications or experience
You will also need an English language qualification (see below)
Qatar
Bachelor's degree with a minimum CGPA of 2.75/4.0 in an engineering, science, medicine, or health subject
or
demonstrated professional or relevant qualifications or experience
You will also need: an English language qualification (see below)
South Africa
Second class division 2 / 60% in a Bachelor's degree with Honours in an engineering, science, medicine, or health subject
or
Second class division 1 / 70% in an Ordinary Bachelor's degree in an engineering, science, medicine, or health subject
or
demonstrated professional or relevant qualifications or experience
You will also need: an English language qualification (see below)
Sri Lanka
55% in a Special Bachelor's degree in an engineering, science, medicine, or health subject
or
demonstrated professional or relevant qualifications or experience
You will also need: an English language qualification (see below)
Turkey
A CGPA of 2.5/4.0 in a Bachelor degree (Lisans Diplomasi) in an engineering, science, medicine, or health subject
or
demonstrated professional or relevant qualifications or experience
You will also need: an English language qualification (see below)
UAE
Bachelor's degree with a CGPA of 2.5/77%/B- in an engineering, science, medicine, or health subject
or
demonstrated professional or relevant qualifications or experience
You will also need: an English language qualification (see below)
Uganda
Second class degree in an engineering, science, medicine, or health subject
or
demonstrated professional or relevant qualifications or experience
You will also need: an English language qualification (see below)
USA
Bachelor's degree with a minimum CGPA of 2.6 in an engineering, science, medicine, or health subject
or
demonstrated professional or relevant qualifications or experience
You will also need: an English language qualification (see below)
Zimbabwe
Second class degree in an engineering, science, medicine, or health subject
or
demonstrated professional or relevant qualifications or experience
You will also need: an English language qualification (see below)
English language requirements
All of our courses require an English language qualification or test. For most students, this requirement can be met with a 4 or C in GCSE English. Please see our English Language guidance pages for further details, including English language test information for international students. For those students who require an English language test, this course requires a test from Group C.
References
Normally, you will need to provide at least one academic reference to support your application unless you have been out of study longer than two years. If it has been more than two years since you last studied on a degree-level programme, you will normally need to provide an employment reference instead. For more information about Academic References, please see our Postgraduate how to apply web pages.
Personal Statement/Statement of Purpose
Please see our Postgraduate how to apply web pages for guidance on what to include in your personal statement.
Recognition of Prior Learning
The Recognition of Prior Learning (RPL) is a process which enables applicants to receive recognition and formal credit for learning acquired in the past through formal study or work and life experiences.
RPL can also be requested for admission onto the start of a programme in lieu of the admission requirements. For more information, see our Recognition of Prior Learning web pages.
Professional qualifications and work experience
The majority of our courses will consider relevant work experience and/or professional qualifications at the appropriate level, as an alternative to an undergraduate degree for entry. The work experience should be for a sustained period and at a suitable level, based within a relevant sector to your chosen course.
Admissions staff will review your work experience and/or professional qualifications during the assessment of your application to ensure suitability in terms of relevancy, level and appropriate learning outcomes.
General information
The entry grades outlined in this section indicate the typical offer which would be made to candidates, along with any subject specific requirements. This is for general information only. Keele University reserves the right to vary offer conditions depending upon a candidate's application. For international students, find out how we work with approved agents as part of our admissions process.
Social life, societies and sports
Find out moreAccommodation
Find out moreLocal area and travel
Find out moreBoost your employability
Find out morePostgraduate funding and scholarships
Funding
Whether you're continuing from undergraduate study or returning to education, our dedicated financial support team is here to help.
We are committed to rewarding excellence and potential. Please visit our scholarships and bursaries webpage for more information.
Please note, if your course offers a January start date, the January 2026 start date falls in the 2025/26 academic year. Please see the tuition fees archive for the 2025/26 fees.
Planning your funding
It's important to plan carefully for your funding before you start your course. Please be aware that not all postgraduate courses and not all students are eligible for the UK government postgraduate loans and, in some cases, you would be expected to source alternative funding yourself. If you need support researching your funding options, please contact our financial support team.
For continuing students, fees will increase annually by RPIX, with a maximum cap of 5% per year.
Additional costs
You do not need to budget for additional mandatory or optional costs beyond standard study expenses. For general information, see the university's additional costs information.
Your career
The global regenerative medicine market size is expected to reach USD 172.15 billion by 2030 in response to the growing demand for novel regenerative therapies, fuelled by advances in cell biology, genomics research and gene-editing technology.
Purposefully tracked to the emerging regenerative medicine industry, our MSc Cell and Tissue Engineering programme has been designed to prepare you for an exciting future within a range of medical engineering areas, be that in academic or industrial research, regulation and governance, medical materials, devices, therapeutics sectors, or in the clinical arena that aligns to this field of medicine.
The modular structure of the course, with flexibility to choose from a wide range of optional modules, allows you to tailor the course to suit your career aspirations, building on your existing strengths and interests, while developing understanding in key topics. This can open up further career opportunities in the pharmaceutical and biotechnology sectors, for example, in bioengineering research.
This is an ideal option for intercalating students who wish to undertake research training in field and an excellent route for those who wish to pursue specialist clinical training or continue their research training in medicine and register for a PhD, typically a requirement to work in the sector.
Positions may include:
- Academic (PhD, Teaching careers)
- Research Trainee/Fellow
- Industrial Research Scientist/Analyst
- Drug Development Scientist
- Clinical Research Scientist
- Medical Degree
- Biomedical Engineer/Scientist
- Geneticist
- Scientist in GMP labs (R&D)
- Scientist in Cell/Gene Therapy labs (R&D)
- Scientist in Pharma (R&D)
- Research Technician
- NHS Biomedical Scientists
- Medical Laboratory Scientist
- Clinical Trials Researcher/Coordinator
- Clinical Operations Researcher
- Scientific Sales Representative
- Product Development Scientist
- Bioinformatician
- Microfluidic scientist
- Synthetic Biologist
- Computational Biologist
- Cell processing and manufacturing specialist
- Biophysicist
- Grant writer
- Science Entrepreneur
- Scientific Consulting
Teaching, learning and assessment
How you'll be taught
The course is primarily taught through subject-centred lectures, interactive-styled conferences, seminars and laboratory-based sessions.
This is supported by a range of workshops, tutorials, guest lectures and research seminars by nationally and internationally known scientists, engineers and clinicians, working at the forefront of regenerative medicine. Previous seminars have been led by academic researchers and industry partners on a range of current topics related to the course discipline.
All modules have some form of practical element, capitalising on our state-of-the-art cell culture labs and tissue engineering facilities, and exposing you to the same specialist equipment and services found in this sector. Where possible, you'll be given opportunities to engage with industry experts, attend site visits to companies and research laboratories, and instigate a conversation with relevant stakeholders.
At Keele, we are proud to showcase how research from bench to clinic works. Using an exemplar of doing exactly that, our sister site the RJAH hospital in Oswestry, is only one of a very few sites in the country that was approved by NICE to administer ACI (Autologous Chondrocyte Implantation) to treat articular cartilage defects of the knee. As a result, on this course, you will have opportunities to appreciate elements of this application and to interact with academics involved as part of our taught modules.
Allocated at the start of your studies, your academic mentor will provide pastoral support and your Course Director will guide you through the year by engaging you in a personal development plan that culminates with students recognising their employability skills and career options. You'll also receive dedicated project supervision during the Summer projects. As well as web-based virtual learning materials, you’ll have full access to two libraries, online journal access and a suite of dedicated computers for exclusive use by MSc students on the course.
Teaching schedule
Teaching takes place over the first two semesters. There are no formal group classes during Semester 3, but you consult with supervisors and access the University’s learning and teaching facilities and support services.
- Semester 1 runs from the end of September to the end of January, with an assessment period in January.
- Semester 2 runs from the last week of January to the end of May with the assessment period in May.
- Semester 3 runs from the end of May to mid-September.
For January intake (students starting from Semester 2 in January), students will proceed as per module and assessment schedule in the respective semesters of a standard September start, except that for these students course runs from January to December.
How you’ll be assessed
Modules are assessed by a mixture of assessment methods, including lab reports, essays, presentations and online examinations to demonstrate your understanding of subject-specific content, as well as your analytical abilities and your evaluation of particular concepts and methodologies. Formative assessment occurs in a continuous process driven by lecturer-led discussion sessions, one-on-one mentoring, and practice presentations and posters.
As part of the course provision, you will have opportunity to follow styles of journal articles in your assignments. Such assessment ensures your competency in essential academic skills, such as referencing, quoting, selecting relevant material, answering the question set, and written English, vital if you intend to pursue a research career. However, it also helps you develop a range of essential transferrable skills, such as problem-solving and critical thinking, time management and planning, written and verbal communication and numeracy.

Keele Postgraduate Association (KPA)
A focal point for the social life and welfare needs of all postgraduate students during their time at Keele.
Keele Postgraduate Association (KPA) is a Students’ Union that specialises in representing the interests of postgraduate students. With a dedicated home at the KPA Clubhouse, a popular venue on campus for students, staff and residents alike – the KPA offers support, advice and a welcoming community for postgraduates.
Our expertise
Teaching staff
Research within the School bridges the interface between new advances in science and technology with medicine and clinical practice, bringing together biological scientists, physicists, chemists, engineers, mathematicians and clinicians. Our exceptional track record in bench and bedside regenerative medicine research builds on the reputation and success of the former Institute for Science and Technology in Medicine (ISTM) which has now integrated within the School.
Our course taps expertise from a variety of internal and external academics, renowned in their particular areas of research, to deliver teaching on a range of topics for core and elective modules, providing flexibility in the breadth of topics you can choose to study via optional modules. You’ll have access to hear from guest lecturers about current developments in the field of stem cell technology and bioengineering. Recent external speakers have included Professor Sian Harding (Cardiac regenerative Medicine at Imperial College London), Professor Sarah Cartmell (Biomaterials at the University of Manchester), Professor Aldo Bocaccini (Tissue engineering at FA University, Erlargen, Nuremberg).
Teaching team includes:
Dr Vinoj George, Course Director and Lecturer – His research interest is in understanding and modulating mechanisms associated with cardiovascular cell biology and cardiovascular diseases, with the aid of genome engineering in human Induced Pluripotent Stem Cells (hiPSCs).
Dr Nicholas Wragg, Lecturer in Bioengineering – His research is focused on complementary areas of regenerative medicine: Musculoskeletal Tissue Engineering, and Regenerative Medicine Biomanufacturing and Process Development.
Professor Ying Yang, Professor in Biomaterials and Tissue Engineering – Ying's current research has been focused on the application of engineering strategies in translational medicine. This includes smart nanofiber design and applications, detection of variation of cell adhesion capacities, developing immune modulating materials, exploring unique techniques to detect heterogeneous cellular populations and correlating the structures of collagen based matrices to diseases.
Professor Neil Telling, Professor of Biomedical Nanophysics – Neil’s current research focuses on two main themes: the fabrication, functionalisation, reactivity and application of magnetic nanostructures in the biomedical sciences; and investigations of biomineralised nanoscale minerals related to neurodegenerative disorders.
Professor Peter Ogrodnik, Senior Lecturer in Medical Devices Design – a Chartered Mechanical Engineer, Peter has conducted research into optimising the treatment of tibial fractures for over 20 years. Having founded two medical device companies himself, he has enhanced the application of engineering design principles to the solution of medical devices and his book Medical Devices Design is a core text in core R&D departments. In 2021, he received the Inspire, Support, Achieve Award from the Institution of Engineering Designers for his work to establish the charity ENG4, providing engineering solutions relating to healthcare during the Covid-19 pandemic.
Dr Gianpiero Di Leva, Senior Lecturer in Molecular Biology – His research focuses on his long-standing interest in exploring the molecular roles of non-coding RNAs (ribonucleic acid) in determining cell fate changes and gene regulation. He aims to identify vulnerabilities in cancer cells and define innovative way to target them.
Dr Jan-Herman Kuiper, Senior Lecturer in Biomechanics – Jan has extensive experience in the use of Finite Element-based computer models for design optimisation, modelling of hydrated tissues and bone, and biological processes such as adaptive bone remodelling and fracture repair. One of his long standing interests is the control of biological processes through mechanical conditions, in particular, mechanical guidance of skeletal tissue formation, and the development and pre-clinical testing of joint replacement implants, bioresorbable orthopaedic devices and bone substitution products.
Dr Wen-Wu Li, Senior Lecturer in Analytical Biochemistry – Having previously worked on anticancer drug discovery and development in Chengdu Diao Pharmaceutical Group, China, Wen-Wu’s research explores drug discovery and development, as well as bioengineering of peptides and antibodies for biomedical application in cancer and infectious diseases.
Dr Abigail Roberts, Lecturer in Biomedical Engineering – Abigail’s research interests are multidisciplinary; utilising bioengineering, spectrometry and spectroscopy to advance healthcare technologies and understanding. Primary focuses are to move analytical technology and practices to the non-invasive or non-destructive routes.
Professor Karina Wright, Professor in Orthopaedics and Tissue Engineering – Focused on developing biological therapies for orthopaedic and spinal cord injury patients.
Dr Alan Richardson, Reader in Pharmacology – Alan leads teaching of pharmacology, including option topics focusing on oncology molecular therapeutics, and as the Group Lead for the Cancer Research Group, his research seeks to discover new treatments for cancer with a major focus on ovarian cancer.
Dr Alan Harper, Senior lecturer in Physiology – His research interests lie in the calcium signalling mechanisms that control the activation and aggregation of human platelets in responses to physiological stimuli, which allows them to clot upon damage to the blood vessel wall. This can also trigger them to clot inside intact, inflamed blood vessels, causing deep vein thrombosis, pulmonary embolism, heart attack and stroke.
Dr Oksana Kehoe, Senior Lecturer in Inflammation Biology – Oksana’s research is focused on understanding mechanisms of rheumatoid arthritis progression and possible treatments, including mesenchymal stem cells (MSCs), mesenchymal stem cell conditioned medium and mesenchymal stem cell-derived extracellular vesicles.
Dr Charlotte Hulme, Lecturer in Regenerative Medicine – Her work focuses on using ‘omic (transcriptomic, quantitative proteomics and metabolomics) and bioinformatics approaches coupled with biochemical/ molecular biology techniques to address significant questions in orthopaedics.
Dr Tina Dale, Lecturer in Applied Biomedical Science.
Dr Pooya Davoodi, Lecturer in Pharmaceutics
Facilities
We are located on Keele University campus and the Guy Hilton Research Centre in Hartshill with additional laboratories and facilities at three main NHS hospitals; University Hospitals of North Midlands (UHNM), Robert Jones and Agnes Hunt (RJAH) Orthopaedic Hospital, Oswestry and the Haywood Hospital, Stoke on Trent.
Guy Hilton Research Centre
The Guy Hilton Research Centre, which opened in 2006, provides extensive facilities for postgraduate taught and researchers at the heart of a research-active environment. This includes a dedicated teaching room for MSc students, where most of the teaching for modules will be conducted and a large study/computer suite for PhD/MPhil/DM students with 24/7 access and Wi-Fi.
As well as generic laboratories, specialist facilities include dedicated labs for biomaterials and bioreactors, a class 100 clean room for supporting research, and molecular facilities which support the advanced biotechnology, drug development, development of magnetic nanotechnology in therapeutics and diagnostics, and SIFT-MS (selected ion flow tube mass spectrometry) technology for breath analysis.
Please note, the Guy Hilton Research Centre is based in Hartshill, Stoke-on-Trent, and is roughly a 30 minute journey from Keele campus by bus.
Proteomic Mass Spectrometry facility
Run in collaboration with Guy Hilton Research Centre (GHRC) and the Robert Jones and Agnes Hunt Orthopaedic Hospital (RJAH) in Oswestry, this facility offers a range of mass spectrometry equipment based at Huxley Building on Keele campus. Providing proteomics and mass spectrometry services for UK based researchers, equipment includes a 4800 MALDI TOF/TOF and 3200 QTRAP tandem quadrupole mass spectrometers, with nanoflow HPLC interfaces.
Central Science Laboratory (CSL)
The University’s £34m Central Science Laboratory (CSL) opened its doors to students in September 2019 and provides 5,300m2 of modern, co-located science laboratories. Over £2m alone has been spent on industrial research-grade analytical and laboratory equipment that will be used by students in their day-to-day laboratory teaching. Access to state-of-the-art facilities and high specification equipment will ensure you are well prepared for scientific or industrial employment post-graduation. The environment mirrors the multi-faceted nature of working life and the shared space allows group working and collaboration between disciplines, building the skills and experience much valued by employers.
David Weatherall Laboratories
These multi-users laboratories house equipment for histology, physiology, pharmacology, biochemistry and microbiology practicals. Here students learn to use stethoscopes, sphygmomanometers, microscopes, computerised spirometry, ECG and EMG equipment, make accurate drug dilutions, and gain skills in basic life support on resuscitation manikins. Facilities are also available to learn sterile technique, ophthalmoscopy, otoscopy and drug delivery. The IT laboratory, which has extended opening hours, houses over 50 networked PCs with additional facilities for digital imaging, scanning, and printing.